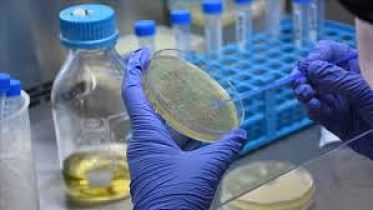

Ministro británico asegura que en el mundo hay cerca de 4.000 variantes de coronavirus
El ministro de Vacunas del Reino Unido, Nadhim Zahawi, aseguró este jueves que existen aproximadamente 4.000 variantes de coronavirus en todo el mundo y adelantó que el Gobierno británico está almacenando una "biblioteca" de mutaciones del virus, para actualizar rápidamente las vacunas si fuera necesario.
En declaraciones a la cadena de televisión Sky News, el funcionario dijo que se han identificado variantes en California,
...Variante Delta del Covid afecta más a los jóvenes en El Día
100 días de Biden, un profundo cambio en el rumbo de EEUU en El Día
El mundo supera los tres millones de muertos por coronavirus en El Día
Reino Unido comenzó a vacunar contra el coronavirus a menores de 50 años en El Día
América Latina supera los 25 millones de contagios en El Día
La pandemia se acelera y América Latina supera los 25 millones de casos en El Día
México, el desastre del que nadie habla en El Día
Afirman que existen 4.000 variantes del coronavirus en El Día
Piden a la población que 'no salgan de casa' si viven en áreas donde se detectó la cepa sudafricana en El Día
